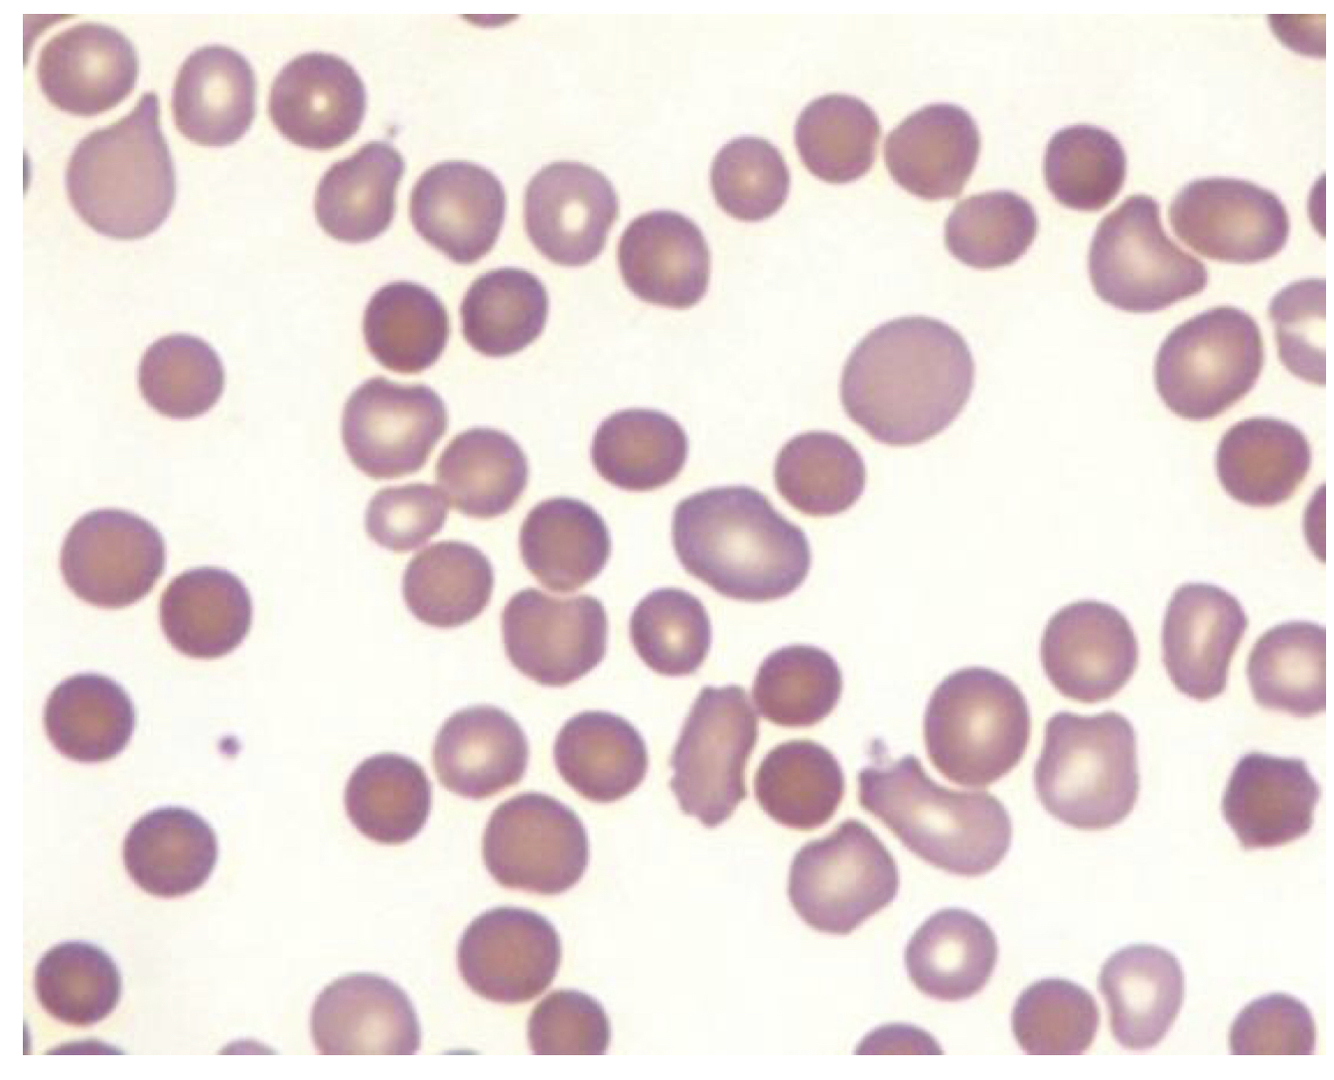
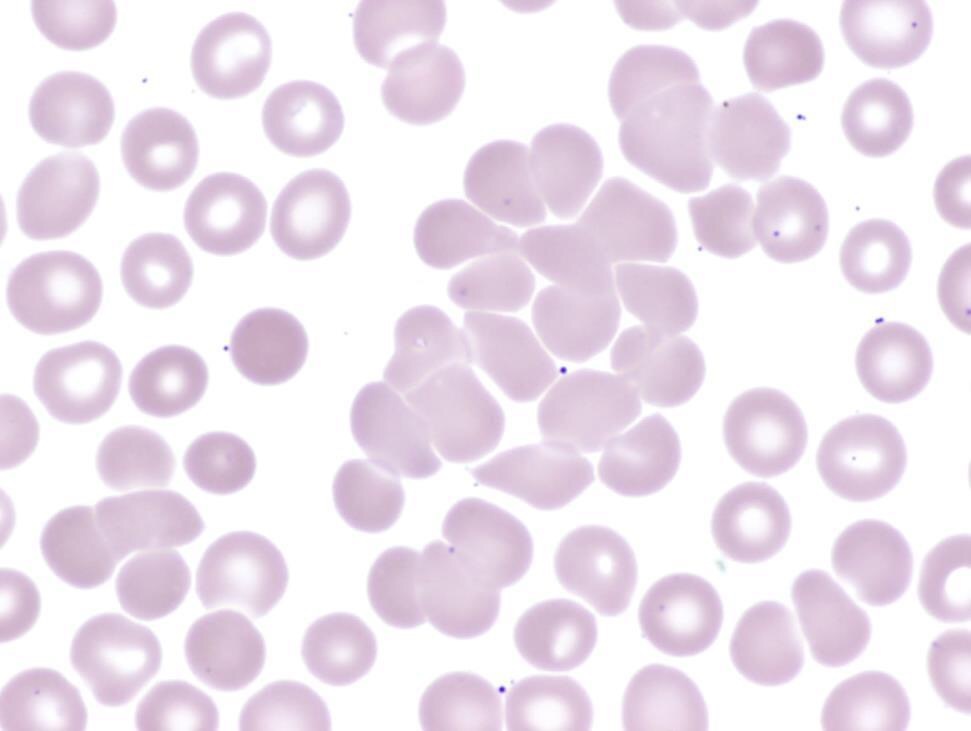
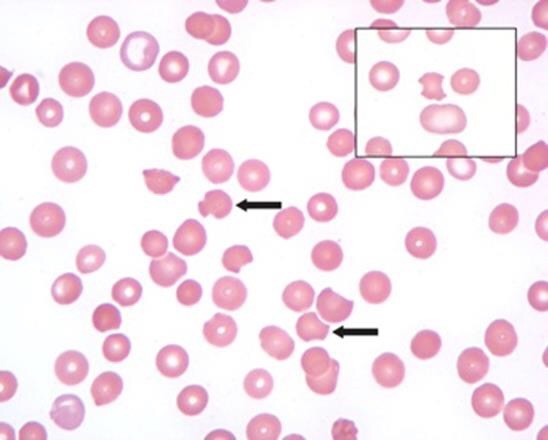

What pathology does this image show?
Spherocytes! (normal sized RBCs with increased Hb concentration… less flexible and shortened life span)
What is the most likely RBC parameter associated with spherocytes? What are 3 major diseases that can cause this?
Increased mean cell Hb concentration (MCHC)
**could be hereditary spherocytosis (inherited), autoimmune hemolytic anemia, or thermal injury (acquired)
What are 3 examples of congenital RBC membrane disorders?
Hereditary:
- sherocytosis
- elliptocytosis
- pyropoikilocytosis
What is the pathogenesis of hereditary spherocytosis?
Unstable membrane forms blebs which are cleaved off by macrophages… this results in membrane loss but no change in RBC volume

How common is hereditary spherocytosis? What are the possible defects that cause it?
- most common inherited hemolytic anemia in the US (1/5000)
- primarily defects in:
- ankyrin (most common)
- alpha/beta spectrin
- band 3 or band 4.2
- most patients have deficiencies in BOTH ankyrin and spectrin (without ankyrin to support spectrin you also develop a spectrin deficiency)
What are the clinical features of hereditary shperocytosis?
- wide variability in severity of hemolysis (asymptomatic incidental finding to severe)
- splenomegaly
- aplastic crisis (red cell aplasia results from parvovirus infecting/killing erythroid precursors)
How do you diagnose hereditary spherocytosis?
- family history
- peripheral blood review (spherocytes) with negative direct antiglobulin test (neg means it’s not autoimmune/acquired!)
- osmotic fragility (old)
How do you manage a patient with hereditary spherocytosis?
- depends on clinical severity
- manage chronic hemolysis (gallstones, jaundice, folate supplementations)
- aplastic crisis
- splenectomy (complete in adults, partial in children < 6) **spleen is taking RBCs out of circulation because of their abnormal membrane… if we remove it we allow the spherocytes to carry oxygen like normal RBCs because there’s nothing functionally wrong with them!
What is DAT?
The direct antiglobulin test (you add antibodies to a sample of a patient’s blood that detect the anti-RBC antibodies causing the disease)

What are some major features of autoimmune hemolytic anemias (AIHAs)
- host Abs reactive with autologous RBCs
- shortened in vivo RBC survival
- exceptions= positive DAT without hemolysis and cold agglutinins
- classified according to optimal temperature of antibody activity
- warm= 37 C
- cold= 0-5 C (not functional in vivo)
Describe warm autoantibody AIHA
- ~80% of all AIHAs
- idiopathic/primary (60%)
- secondary (40%)
- lymphoproliferative disorders
- autoimmune disorders
- non-hematopoietic neoplasms (e.g. ovarian cancer)
- drugs (e.g. alpha methyldopa, cephalosporins)
Describe cold autoantibody AIHA
- ~20% of all AIHAs
- idiopathic
- secondary
- lymphoproliferative disorders
- postinfectious (e.g. infectious mononucleosis, mycoplasma)
What is the pathogenesis of AIHAs?
- warm
- Antibody (IgG) or complement mediated extravascular hemolysis
- spherocyte production
- cold
- IgM mediated agglutination (impedes blood flow in superficial distal vessels)
- IgM and complement mediated RBC injury (extravascular AND intravascular hemolysis)
What is seen in this image?
Cold agglutinins (may be seen in cold AIHA… usually doesn’t cause anemia but may cause obstructive symptoms)
What are the clinical symptoms of warm AIHA?
**She said to know this!!
- anemia symptoms mild to severe (with massive hemolysis)
- organomegaly
What are the clinical symptoms of cold AIHA?
**she said to know this!
- acute form 2-3 weeks into infectious illness (EBV= anti-i or mycoplasma= anti-l)
- chronic form is associated with lymphoproliferative disorders
- follows cold exposure
- anemia symptoms mild to severe (with massive hemolysis)
- acrocyanosis
- raynaud phenomenon
How do you manage AIHA?
- warm
- decrease the production of autoantibody
- immunosuppression (steroids such as prednisone first, then consider splenectomy or rituximab)
- cold
- treat any underlying malignancy or infection
- warm the patient
- usually refractory to immunosuppression
- if drug mediated, stop the drug!
What does this image show? What could cause this morphology?
Bite cells! Can be secondary to mononuclear cell phagocytosis of denatured proteins (due to oxidative stress)
What are 2 major congenital red cell enzyme disorders and what pathways do they affect?
- glucose 6 phosphate dehydrogenase deficiency (pentose phosphate pathway)
- pyruvate kinase deiciency (glycolysis)
Describe G6PDH deficiency
- defect in the pathway responsible for reducing oxidants
- build up of G6P
- decreased glutathione production
- inability to reduce oxidant stressors
- oxidant stressors= infection, fava beans, drugs
- RBCs affected (resulting in hemolytic anemia)

What is a Heinz body?
- Denatured hemoglobin that directly damages the RBC (leading to intravascular hemolysis)
- NOT observable on a peripheral blood smear
- Heinz bodies removed in the spleen causing bite cells and spherocytes (leading to extravascular hemolysis)
What drugs are known oxidant stressors?
- dapsone
- sulfonamides
- primaquine
- nitrofuantoin
- quinolones
How common is G6PDH deficiency? What are some variants?
- 400 million people affected worldwide
- common in malarial endemic areas (resistance)
- X-linked
- 400+ protein variants, specific to ethnicities with variable enzyme activities

Describe G6PD A-
- 11% of african american males
- leads to unstable enzyme
- 100% activity in new RBCs
- 5-15% activity in “old” RBCs (120 day lifespan normally)
- self limited hemolysis upon oxidant exposure
- “old” RBCs hemolyze
- reticulocytes and new RBCs don’t hemolyze








